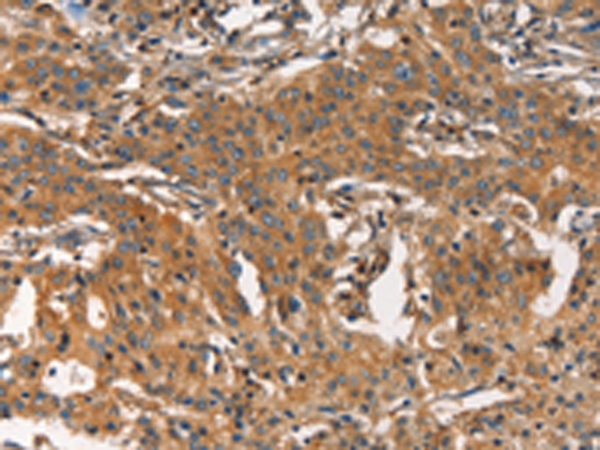
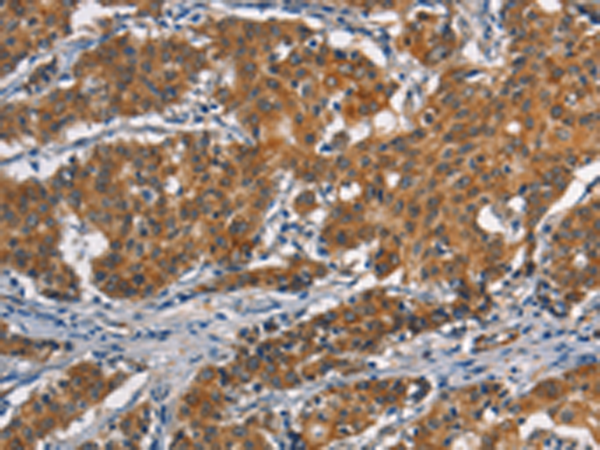

-
分类: 科研抗体货号: P11181别名: AMD; SAMDC; ADOMETDC应用: IHC反应种属: Human, Mouse, Rat
-
分类: 科研抗体货号: P11158别名: Fz-3应用: IHC反应种属: Human, Mouse
-
分类: 科研抗体货号: P11178别名: AR; ADR; ALR2; ALDR1应用: WB,IHC反应种属: Human
-
分类: 科研抗体货号: P11198别名: ARC20; P20-ARC应用: WB,IHC反应种属: Human, Mouse
-
分类: 科研抗体货号: P11157别名:应用: IHC反应种属: Human
-
分类: 科研抗体货号: P11177别名: ALR; ARM; DD3; ALDR1应用: WB,IHC反应种属: Human, Mouse, Rat
-
分类: 科研抗体货号: P11197别名: ARC34; PRO2446; p34-Arc; PNAS-139应用: WB,IHC反应种属: Human, Mouse, Rat
-
分类: 科研抗体货号: P11155别名: NFAT1; NFATP应用: IHC反应种属: Human, Mouse
-
分类: 科研抗体货号: P11176别名: ART; AGRT; ASIP2应用: IHC反应种属: Human
-
分类: 科研抗体货号: P11196别名: APOL; APO-L; FSGS4; APOL-I应用: WB,IHC反应种属: Human

鄂公网安备42018502007531号
鄂公网安备42018502007531号

